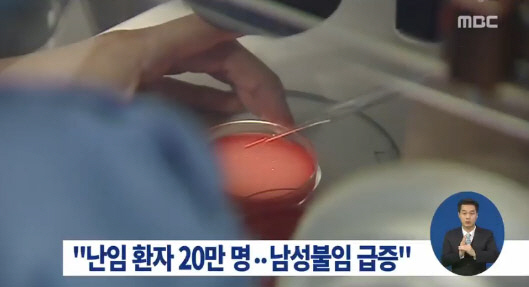

난임 환자 20만명
정부가 출산율을 높이기 위해 난임 환자의 진료 지원 규모를 늘려가고 있지만 임신이 어려운 난임 환자의 수가 늘고 있다고 나타났다. 특히 여성보다 남성 환자의 수가 괄목적인 증가세를 보이고 있는 것이 확인됐다.
국회 보건복지위원회 소속 새누리당 박윤옥 의원은 20일 보건복지부의 난임 부부 현황 자료를 분석한 결과, 지난 2007년 17만8000여명이던 난임 환자 수는 2014년 20만8000여명으로 16%가량 증가한 것으로 조사됐다.
특히 남자 환자의 증가세가 여자 환자의 증가세보다 더 큰 것으로 밝혀졌다. 같은 기간 조사에서 여자 환자는 14만9,000여명에서 15만6,000여명으로 7%가량 증가했으나 남자 환자는 2만8,000여명에서 4만4,000여명으로 67%가량 늘었다.
박윤옥 의원은 "저출산 문제가 심각한 우리나라에 난임 부부가 지속적으로 늘어나는 것은 사회적으로 더 큰 문제가 될 수 있다"며 "난임 치료에 건강보험 적용이 확정된 것에 더해 꾸준하고 적극적인 지원이 필요하다"고 강조했다. <스포츠조선닷컴>
난임 환자 20만명 난임 환자 20만명 난임 환자 20만명